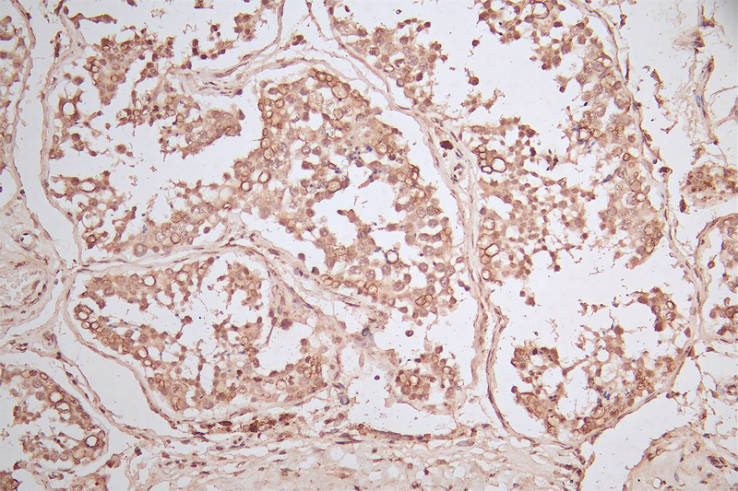

-
中文名稱:ERBB2重組抗體
-
貨號:CSB-RA007763MA2HU
-
規格:¥1320
-
圖片:
-
IHC image of CSB-RA007763MA2HU diluted at 1:600 and staining in paraffin-embedded human breast cancer performed on a Leica BondTM system. After dewaxing and hydration, antigen retrieval was mediated by high pressure in a citrate buffer (pH 6.0). Section was blocked with 10% normal goat serum 30min at RT. Then primary antibody (1% BSA) was incubated at 4°C overnight. The primary is detected by a Goat anti-Mouse IgG labeled by HRP and visualized using 0.05% DAB.
-
IHC image of CSB-RA007763MA2HU diluted at 1:600 and staining in paraffin-embedded human testis tissue performed on a Leica BondTM system. After dewaxing and hydration, antigen retrieval was mediated by high pressure in a citrate buffer (pH 6.0). Section was blocked with 10% normal goat serum 30min at RT. Then primary antibody (1% BSA) was incubated at 4°C overnight. The primary is detected by a Goat Goat anti-Mouse IgG labeled by HRP and visualized using 0.05% DAB.
-
-
其他:
產品詳情
-
產品描述:ERBB2 Recombinant Monoclonal Antibody(CSB-RA007763MA2HU)是針對人源ERBB2/HER2蛋白開發的高特異性單克隆抗體。ERBB2作為表皮生長因子受體家族成員,在細胞信號轉導和腫瘤發生中發揮關鍵作用,其異常表達與多種實體瘤的發生發展密切相關。本抗體通過重組表達技術制備,經ELISA和免疫組化(IHC)嚴格驗證,在IHC應用中表現出優異的組織特異性染色效果,推薦使用稀釋度為1:50-1:200,可清晰顯示目標蛋白在石蠟包埋組織切片中的亞細胞定位。該產品具有高度均一的批次穩定性,適用于癌癥分子機制研究、腫瘤標志物篩選及靶向分子探針開發等科研領域,為探索ERBB2相關信號通路調控、腫瘤微環境分析及藥物作用機制等實驗提供可靠工具。
-
Uniprot No.:
-
基因名:
-
別名:Verb b2 erythroblastic leukemia viral oncogene homolog 2, neuro/glioblastoma derived oncogene homolog antibody; C erb B2/neu protein antibody; CD340 antibody; CD340 antigen antibody; Cerb B2/neu protein antibody; CerbB2 antibody; Erb b2 receptor tyrosine kinase 2 antibody; ErbB-2 proto-oncogene antibody; ERBB2 antibody; ERBB2_HUMAN antibody; HER 2 antibody; HER 2/NEU antibody; HER2 antibody; Herstatin antibody; Human epidermal growth factor receptor 2 antibody; Metastatic lymph node gene 19 protein antibody; MLN 19 antibody; MLN19 antibody; NEU antibody; NEU proto oncogene antibody; Neuro/glioblastoma derived oncogene homolog antibody; Neuroblastoma/glioblastoma derived oncogene homolog antibody; NGL antibody; p185erbB2 antibody; Proto-oncogene c-ErbB-2 antibody; Proto-oncogene Neu antibody; Receptor tyrosine-protein kinase erbB-2 antibody; TKR1 antibody; Tyrosine kinase type cell surface receptor HER2 antibody; Tyrosine kinase-type cell surface receptor HER2 antibody; V erb b2 avian erythroblastic leukemia viral oncogene homolog 2 (neuro/glioblastoma derived oncogene homolog) antibody; V erb b2 avian erythroblastic leukemia viral oncogene homolog 2 antibody; V erb b2 avian erythroblastic leukemia viral oncoprotein 2 antibody; V erb b2 erythroblastic leukemia viral oncogene homolog 2, neuro/glioblastoma derived oncogene homolog (avian) antibody; V erb b2 erythroblastic leukemia viral oncogene homolog 2, neuro/glioblastoma derived oncogene homolog antibody; Verb b2 erythroblastic leukemia viral oncogene homolog 2, neuro/glioblastoma derived oncogene homolog (avian) antibody
-
反應種屬:Human
-
免疫原:A synthesized peptide derived from Human ERBB2
-
免疫原種屬:Homo sapiens (Human)
-
標記方式:Non-conjugated
-
克隆類型:Monoclonal
-
抗體亞型:Mouse IgG
-
純化方式:Affinity-chromatography
-
克隆號:25E7
-
濃度:It differs from different batches. Please contact us to confirm it.
-
保存緩沖液:Preservative: 0.03% Proclin 300
Constituents: 50% Glycerol, 0.01M PBS, PH 7.4 -
產品提供形式:Liquid
-
應用范圍:ELISA, IHC
-
推薦稀釋比:
Application Recommended Dilution IHC 1:50-1:200 -
Protocols:
-
儲存條件:Upon receipt, store at -20°C or -80°C. Avoid repeated freeze.
-
貨期:Basically, we can dispatch the products out in 1-3 working days after receiving your orders. Delivery time maybe differs from different purchasing way or location, please kindly consult your local distributors for specific delivery time.
-
用途:For Research Use Only. Not for use in diagnostic or therapeutic procedures.
相關產品
靶點詳情
-
功能:Protein tyrosine kinase that is part of several cell surface receptor complexes, but that apparently needs a coreceptor for ligand binding. Essential component of a neuregulin-receptor complex, although neuregulins do not interact with it alone. GP30 is a potential ligand for this receptor. Regulates outgrowth and stabilization of peripheral microtubules (MTs). Upon ERBB2 activation, the MEMO1-RHOA-DIAPH1 signaling pathway elicits the phosphorylation and thus the inhibition of GSK3B at cell membrane. This prevents the phosphorylation of APC and CLASP2, allowing its association with the cell membrane. In turn, membrane-bound APC allows the localization of MACF1 to the cell membrane, which is required for microtubule capture and stabilization.; In the nucleus is involved in transcriptional regulation. Associates with the 5'-TCAAATTC-3' sequence in the PTGS2/COX-2 promoter and activates its transcription. Implicated in transcriptional activation of CDKN1A; the function involves STAT3 and SRC. Involved in the transcription of rRNA genes by RNA Pol I and enhances protein synthesis and cell growth.
-
基因功能參考文獻:
- This abnormally sensitive electrochemical sensing performance resulting from anionic porphyrin for DNA sequences specific to HER2 gene will offer considerable promise for tumor diagnosis and treatment PMID: 30340409
- Authors showed that mRNA and protein levels of COX2 and HER2 were upregulated in CRC compared with the adjacent tissues. COX2 protein levels and nuclear COX2 expression were correlated with a poor prognosis of CRC patients. COX2 expression was positively associated with HER2 expression. PMID: 29873317
- In patients with HER2-positive advanced breast cancer who have been heavily pretreated with anti-HER2 agents and cytotoxic chemotherapy, trastuzumab emtansine (T-DM1) is well tolerated and provided a meaningful progression-free survival of 6 months and an overall survival that has not been reached. PMID: 29326401
- The expression of C-Met and HER2 protein in lung adenocarcinoma is highly correlated, and whether it is synergistic in the targeted therapy of lung adenocarcinoma deserves further study. PMID: 29400000
- Although ST6GalI overexpression increased HER2 sialylation, corresponding to decreased HER2 phosphorylation, high alpha2,6sialylation enhanced Akt and ERK phosphorylation levels compared to those in the vector cell line; ST6GalI knockdown had the opposite effects. Collectively, these results implicated a functional role of ST6GalI in promoting tumor cell progression and trastuzumab resistance. PMID: 30226606
- Study demonstrate that the miR-495 exerts promotive effects on GC chemosensitivity via inactivation of the mTOR signaling pathway by suppressing ERBB2. The study provides reliable evidence supporting the use of miR-495 as a novel potential target in the chemotherapy of GC. PMID: 30147110
- In early breast cancer, PIK3CA mutations seem to identify HER2+ patients who are less likely to reach pCR. The clinical implications of PIK3CA mutations tend to vary between exon 9 and exon 20. This mechanism should be explored in further studies. PMID: 29575819
- HER2 and HER3 expression was detected in 22.2% and 86.1% of samples, respectively. The frequency of EGFR mutation was 45.7% and was not significantly different between stage 0 and IA1 (40.0% and 48.0%, respectively), suggesting that EGFR mutation does not correlate with cancer progression from stage 0 to IA1. PMID: 29473311
- It has been demonstrated that the heterogeneity of HER2 expression accelerated the development of metastases which caused the poor survival of mice with heterogeneous HER2 expression (HER2-60). PMID: 30042341
- Her-2/neu amplification increases with increasing grade of breast cancer. A high proportion of Her-2/neu gene amplified cases indicates aggressive disease in that area and need for FISH testing on large scale, which is the gold standard for equivocal cases on immunohistochemistry. PMID: 30060783
- Data indicate that the major mechanism is the ability of p140Cap to interfere with ERBB2-dependent activation of Rac GTPase-controlled circuitries. PMID: 28300085
- Study showed the expression levels of Gli1 and HER2 were significantly higher in gastric cancer, and they are positively related. HER2 may regulate Gli1 by Akt-mTOR-p70S6K pathway. PMID: 29321573
- The combination of immunohistochemical expression of BRCA1, ER, PR, and HER-2/neu and clinicopathological details may be helpful in predicting the individuals more likely to carry BRCA1 mutations and thus selecting the candidate and family members for genetic screening for BRCA1 mutations. PMID: 29567881
- In the current settings, HER2/neu is not found to be a prognostic marker in head-and-neck cancers. PMID: 30004046
- These results may be commented as HE4 expression rises in patients with HER2/neu amplification. PMID: 30004048
- HER2 gene amplification in circulating tumor DNA predicts HER2-positive breast neoplasms resistance to trastuzumab emtansine. PMID: 29700710
- Statistical analysis performed in this study did not reveal the significant relationship between HER2 overexpression on the tumor cells and microvessel density in the tumor stroma. PMID: 30334990
- Data showed a high rate of discordance in matched pairs of primary tumors and metastases, suggesting that the accurate evaluation of proto-oncogene protein HER-2 (HER2) status is essential before any therapeutic decision. PMID: 30203148
- HER2 gene amplification occurred during the early stages of gastric cancer and showed heterogeneity in several cases. HER2 gene amplification may be involved in tumor progression in early gastric cancer. PMID: 30120594
- Activating HER2 mutation is present in about 3% of bone metastases from breast cancers, with significantly higher rates in the pleomorphic subtype of lobular cancer. PMID: 30094493
- The results suggested a possible link between tRNALeu overexpression and RSK1/MSK2 activation and ErbB2/ErbB3 signaling, especially in breast cancer. PMID: 28816616
- High HER2 expression is associated with metastasis in breast Cancer. PMID: 29187405
- This study confirmed that biosimilar trastuzumab improves the overall response rate when combined with chemotherapy for HER2+ breast cancer PMID: 30082554
- The Authors reveal a gender difference in the prognostic value of concomitant AIB1 and HER2 copy number gain (CNG) in glioma patients which were barely noticed before. These observations indicated that genetic alterations synergistic with essential respects of sex determination influence glioma biology and patients outcomes. PMID: 30153912
- The survival rates in this study are equal to the documented global rates; nodal disease burden emerged as the most important prognostic factor. In addition, in EBCs, a lack of hormone receptor expression and in LABC, Her2neu overexpression appear to worsen the outcome. PMID: 30147088
- Results showed that HER2 and FGFR2 are regulated by DDX6 at the post-transcriptional step in gastric cancer. PMID: 29987267
- HER2 overexpression is associated with Gastric Cancer. PMID: 29938472
- ERBB2 oncogene at 17q12 is susceptible to palindromic gene amplification in HER2-positive breast tumors. PMID: 28211519
- Results show mutation in ERBB2-exon17 was associated with worse survival results in patients with pancreatic neoplasm. [review] PMID: 30227250
- High HER2 expression and Gene Amplification is associated with Upper Tract Urothelial Carcinomas. PMID: 28755093
- High HER2 expression is associated with invasion and lymph node metastasis in gastric cancer. PMID: 29970682
- Basal HER2 phenotype showed poor DFS, but equivalent pCR rate after concurrent neo-adjuvant chemotherapy with trastuzumab. A different treatment approach to basal-HER2 type is needed even for cases that achieved adequate clinical response after neo-adjuvant chemotherapy. PMID: 29971625
- In the largest series reported to date, patients with HER2-amplified m17 cancers treated with trastuzumab have outcomes comparable to patients from the large phase III adjuvant trastuzumab trials who were HER2-positive, supporting the critical role of HER2-directed therapy in this patient population. PMID: 28986743
- The interplay of dual MET/HER2 overexpression in the AKT and ERK pathways for esophageal cancer is described. Therefore, combination therapy could be a novel strategy for EAC with amplification of both MET and HER2. PMID: 29223420
- Study provides evidence that the hostile environment developed in spheroids has a key role in the acquisition of resistance to Trastuzumab and is associated with an increase in the number of breast cancer stem cells as well as a modulation in HER2 expression. PMID: 28722778
- A major finding of our study is that one out of five (20%) patients with breast cancer BM had a receptor discrepancy between the primary tumor and the subsequent BM, with loss of hormone receptors (ER and/or PR) expression, and gain of HER2 overexpression as the most commonly observed changes PMID: 28975433
- High HER2 expression is associated with Gastric Adenocarcinoma. PMID: 29802704
- Absence of HER2 Expression of Circulating Tumor Cells is associated with Non-Metastatic Esophageal Cancer. PMID: 30275185
- HER2 positivity was found in a minority of rectal cancer patients and was not significantly associated with clinicopathologic and molecular characteristics. PMID: 30056472
- Study discovered a novel enhancer HER2 gene body enhancer (HGE) in the 3' gene body of HER2. The HGE activates promoters 1 and 2 in trans., and hence the TFAP2C-mediated transcriptional induction of HER2 expression in breast cancer samples. PMID: 29035388
- ctDNA gene mutation profiles differed among HR/HER2 subtypes of metastatic breast cancer (MBC) patients. By identifying mutations associated with treatment resistance, we hope to improve therapy selection for MBC patients who received multiline treatment. PMID: 29807833
- It was concluded that miR494 inhibited the cancer initiating cells phenotype and reversed resistance to lapatinib by inhibiting FGFR2 in HER2positive gastric cancer. PMID: 29786108
- HER2 overexpression was evident in nearly 25% of the Malaysian patients with locally advanced or metastatic gastric cancer. The overexpression correlated significantly with male gender and diffuse-type tumors. PMID: 28124769
- There was a statistically significant association between positive p95-HER2 expression and negative hormonal receptors expression (p=0.004), high Ki-67 expression (p<0.001) and development of visceral metastasis PMID: 29779938
- The authors herein prove, for the first time, that the transcriptional repressor Blimp1 is a novel mediator of p130Cas/ErbB2-mediated invasiveness. Indeed, high Blimp1 expression levels are detected in invasive p130Cas/ErbB2 cells and correlate with metastatic status in human breast cancer patients. PMID: 28442738
- ERBB2 amplification is driving resistance to erlotinib in lung adenocarcinoma. PMID: 28870636
- Results showed that combining the results of IHC and FISH according to the HER2 testing algorithm is a useful method for accurately evaluating HER2-positive EMPD. PMID: 29744813
- Because the concordance rates of HER2 IHC score 2/3+ cases were lower than that of HER2 IHC score 0/1+ cases, further studies for detailed analysis criteria for HER2 IHC score 2+ or 3+ are required. PMID: 28478639
- HER2 interacts with Beclin 1 in breast cancer cells and inhibits autophagy. Mice with increased basal autophagy due to a genetically engineered mutation in Becn1 are protected from human HER2-driven mammary tumorigenesis. HER2-mediated inhibition of Beclin 1 and autophagy likely contributes to HER2-mediated tumorigenesis. PMID: 29610308
- These findings suggest that early-stage morphological alterations of HER2-positive BC cells during cancer progression can occur in a physical and signalling-independent manner. PMID: 27599456
顯示更多
收起更多
-
相關疾病:Glioma (GLM); Ovarian cancer (OC); Lung cancer (LNCR); Gastric cancer (GASC)
-
亞細胞定位:[Isoform 1]: Cell membrane; Single-pass type I membrane protein. Early endosome. Cytoplasm, perinuclear region. Nucleus.; [Isoform 2]: Cytoplasm. Nucleus.; [Isoform 3]: Cytoplasm. Nucleus.
-
蛋白家族:Protein kinase superfamily, Tyr protein kinase family, EGF receptor subfamily
-
組織特異性:Expressed in a variety of tumor tissues including primary breast tumors and tumors from small bowel, esophagus, kidney and mouth.
-
數據庫鏈接:
Most popular with customers
-
-
YWHAB Recombinant Monoclonal Antibody
Applications: ELISA, WB, IHC, IF, FC
Species Reactivity: Human, Mouse, Rat
-
Phospho-YAP1 (S127) Recombinant Monoclonal Antibody
Applications: ELISA, WB, IHC
Species Reactivity: Human
-
-
-
-
-